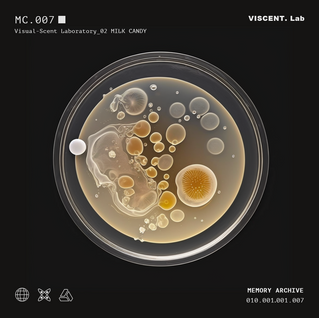
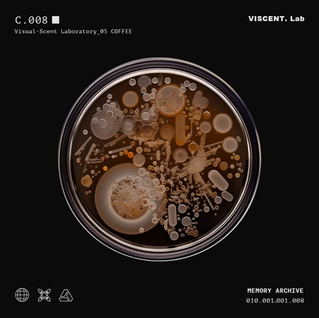
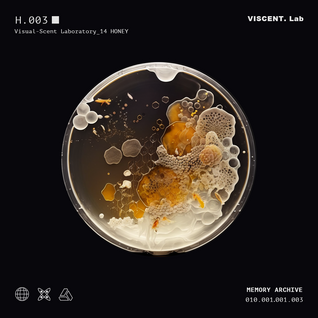
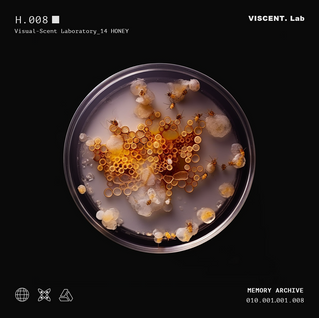
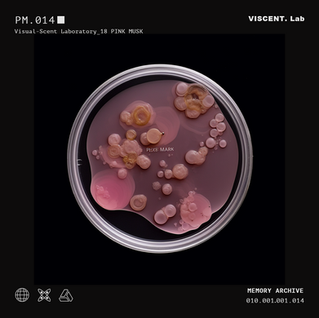

VI-SCENT.Lab ARCHIVING
Tool: Stable Diffusion, Midjourney
Archive 1 - Cucumber

C. 001
This scent reminded me of my younger sister and the times we shared. We lived through similar experiences related to patriarchy, and together we faced them, creating a home full of sisterhood. The fragrance brought back memories of our childhood garden, where we found solace and strength amidst the challenges. Each whiff transports me to those nights under the stars, whispering dreams and hopes.
C. 002
This scent reminded me of family outings to our favorite Thai restaurant. The fresh aroma of cucumber, mingling with lemongrass and herbs, instantly brought back memories of crisp, cool salads and refreshing summer rolls.
C. 003
This scent reminded me of my life in London when I first bought a cucumber-scented lotion. The fresh, crisp aroma of cucumber instantly brought back memories of those early days, filled with both excitement and uncertainty. Each whiff evoked a sense of calm and clarity, providing a soothing escape from the bustling city.

C. 004
The crisp aroma of cucumber whisked me back to my 16-year-old self, when I first discovered Kenzo perfume. This scent captured the essence of my teenage years, filled with excitement and new experiences. Each whiff evoked the thrill of adolescence, bringing back memories of carefree moments with friends, the anticipation of first dates, and the joy of exploring my own style.
C. 005
The scent of rain-soaked grass and earthy soil after a storm reminded me of my childhood summers spent at my grandparents' countryside home. Each whiff transported me back to those carefree days when my siblings and I would run barefoot through the fields, feeling the damp earth beneath our feet.
C. 006
This smell reminded me of my hometown. Each whiff brought back vivid memories of summer days spent in the garden, picking fresh vegetables with my family. The scent evoked a deep sense of nostalgia, recalling the simple pleasures of childhood, the laughter of loved ones, and the comfort of familiar surroundings. It was a powerful reminder of the warmth and simplicity of home, filling me with a sense of belonging and peace.

C. 007
The smell reminded me of my favorite chewing gum from childhood. Every whiff took me back to those carefree days when I’d unwrap a piece and enjoy its cool, refreshing flavor. It brought back memories of hanging out with friends, laughing, and blowing bubbles in the sunshine.
C. 008
The smell of cucumber reminds me of summer. Its cool, clean scent brings back memories of warm, sunny days and the taste of refreshing cucumber slices.
Archive 2 - Milk Candy

MC. 001
The smell brings back memories of my childhood after-school snacks. I miss those carefree days spent with friends, savoring the rich, comforting flavor together.
MC. 002
This smell make me feel comfortable, instantly making me feel relaxed and soothed. It is gentle and calming, reminiscent of my childhood, it takes me back to those peaceful moments, sitting in my favorite spot at home.
MC. 003
A familiar sweetness transports me back to my childhood, reminding me of eating sweets during my school lunch break. The creamy, rich aroma brings back memories of unwrapping caramel candies with friends, the sticky sweetness lingering on our fingers. Each whiff evokes the joy and excitement of those simple times, the laughter and camaraderie we shared.

MC. 004
The rich, creamy scent reminds me of milk candies or cake. It brings back memories of family gatherings and birthday parties. The smell of cream cake takes me back to the feeling of celebrating birthdays as a child, which was the moment I looked forward to the most every year.
MC. 005
I'm instantly transported back to my childhood, standing beside my mum. It's the same comforting scent that used to linger on her, mixed with her favorite floral perfumes. Each whiff brings back those precious moments, evoking the warmth and security I felt as a small boy next to her.
MC. 006
It taking me back to my childhood Chinese New Year celebrations at home. This scent brings back vivid memories of cracking open milk-flavored sunflower seeds with my family. Each whiff evokes the warmth and joy of those festive times, surrounded by loved ones and the comforting aroma of special treats.
MC. 007
It brings to mind my favorite vanilla cookies, instantly transporting me to my grandmother's kitchen. This smell evokes memories of baking sessions with her, where the air was filled with warmth and love. Each whiff makes me feel the comforting presence of those afternoons, the joy of mixing ingredients, and the anticipation of tasting the delicious treats.
MC. 008
I'm not very accustomed to this scent. It smells like milk caramel candies, and I don't like milk candies because I'm lactose intolerant. So whenever I smell this aroma, I feel uncomfortable.
MC. 009
It takes me back to my childhood, reminding me of the milk tablets I used to love. My grandmother always brought them home for me, and we would often buy them together during our trips to the supermarket. The scent recalling the warmth of my grandmother's presence.

MC. 010
The smell reminds me of my big sister. It bringing back memories of her warmth and gentle nature. Each whiff evokes a sense of safety and comfort, as if I'm wrapped in her loving embrace.
Archive 3 - Ginger

G. 001
The scent reminds me of the lemon candies I loved to buy during my middle school years. It takes me back to the after-school times when I would visit the small shop near my school. The shop window was adorned with a variety of colorful candies, and my favorite was the lemon-ginger candy. I loved its bright, translucent yellow color and enjoyed watching the light refract through it in the sunlight.
G. 002
This scent makes me think of the ginger tea and brown sugar water my mom would prepare for me when I had a cold or menstrual cramps. I can almost feel its warmth, steaming hot. Whenever I was sick or in pain, my mom would always make ginger water for me, which eased my discomfort and fatigue.
G. 003
This smells like ginger, and it brings back memories of the lemon-ginger water I used to make, combining lemon and ginger for my afternoon tea. It also reminds me of my home and the summer days spent with my family, enjoying the sunshine and the green lawns.

G. 004
This scent is very similar to what I first encountered when I walked into a Le Labo shop. I love their perfumes and often visit their store.
G. 005
This scent reminds me of summer lemongrass cakes! It’s my favorite cake flavor, especially in summer. I used to buy a few pieces and share them with my friends on the grass, chatting and playing games.
G. 006
This is the scent of my current shower gel. I love this fragrance because it makes me feel refreshed, especially in the summer. I remember there was also a famous shampoo with this scent.
Archive 4 - Forest

G. 007
The smell of ginger candies! It reminds me of the soothing candies I used to have when I had a cold.
G. 008
It smells like an old-fashioned shampoo I used to use. Although it’s been a long time, this scent still brings me back to how I felt when I used it.
G. 009
The sharp, spicy aroma of ginger instantly brings me back to my grandmother's kitchen. Every winter, she would prepare ginger tea for us, filling the house with warmth and a comforting sense of love and care.

G. 010
The scent of ginger reminds me of holiday baking sessions with my mother. We would spend hours making gingerbread cookies, and the kitchen would be filled with laughter and the delightful smell of spices, marking the start of the festive season.
G. 011
The fresh, earthy smell of ginger takes me back to the bustling markets I used to visit with my parents. The vibrant stalls, the chatter of vendors, and the mix of aromas created an exciting and memorable atmosphere that I cherish to this day.
G. 012
The pungent, invigorating scent of ginger reminds me of the home remedies my mom used to make when I was sick. She would brew ginger tea with honey and lemon, and the warm, soothing aroma would fill the house.
Archive 4 - Forest

F. 001
The smell of fallen leaves and moss takes me back to autumn walks in the forest, the crunch of leaves underfoot and the vibrant colors all around.
F. 002
The musty, woody scent of autumn leaves and dampness takes me back to foraging trips with my family, searching for edible mushrooms.
F. 003
The smell brings back memories of finding mushrooms popping up overnight. The ground was soft and the air was cool, filled with the scent of wet earth and fungi.

F. 004
The fresh, earthy scent of pine and damp soil instantly transports me to early morning hikes with my family, where the crisp air and the scent of the forest woke us up to the beauty of nature.
F. 005
The damp, rich aroma of the forest after a rainstorm takes me back to spotting snails emerging from their hiding places.
F. 006
The pungent, invigorating scent of ginger reminds me of the home remedies my mom used to make when I was sick. She would brew ginger tea with honey and lemon, and the warm, soothing aroma would fill the house.

F. 007
The smell of fallen leaves and moss takes me back to autumn walks in the forest, the crunch of leaves underfoot and the vibrant colors all around.
F. 008
The fresh, earthy scent of the forest in the early morning reminds me of seeing snails slowly making their way across dew-covered leaves.
F. 009
The scent of wildflowers and fresh rain in the forest brings back memories of childhood adventures, exploring trails and imagining fantastical worlds among the trees.

F. 010
The moist forest floor after a rain brought back memories of finding snails slowly crawling on wet leaves.
F. 011
The smoky aroma of a campfire mixed with the fragrance of pine needles reminds me of summer camping trips, roasting marshmallows and telling stories under the stars.
F. 012
The damp, earthy scent of the forest in the early morning reminds me of walking through a misty woodland, where clusters of mushrooms dotted the forest floor. The air was filled with the rich smell of damp soil and decaying leaves.

F. 013
It takes me back to an afternoon spent exploring the woods. The ground was soft and the air was filled with the rich scent of wet leaves and soil. As I walked along the path, I spotted snails slowly making their way across the forest floor, their shells glistening with raindrops.
F. 014
This reminds me of finding colorful mushrooms on the forest floor. The fresh, woody smell and the sight of the vibrant mushrooms made my walks in the woods feel magical and special.
F. 015
It takes me back to childhood walks with my family. The ground was a carpet of orange and yellow leaves, and we would kick them up as we walked, enjoying the rustling sound and the earthy smell that filled the air.

F. 016
The cool, humid scent of shaded groves in the forest recalls exploring areas rich with moss and fungi. The air was thick with the smell of decomposing wood and earth, and the sight of various mushrooms growing on fallen logs and tree trunks.
F. 017
The fresh, earthy scent of rain on forest leaves in the summer reminds me of peaceful afternoons spent hiking. As the raindrops fell, the forest came alive with the smell of wet leaves and damp earth.
F. 018
The scent of fallen leaves and earthy soil in autumn brings back memories of watching snails crawl over the colorful foliage.

F. 019
The smell of moist, mossy paths in the forest recalls finding snails nestled among the green carpets of moss.
F. 020
The earthy smell of the forest after a rain takes me back to a hidden clearing filled with butterflies. They fluttered around the wildflowers, making the forest feel alive and enchanting.
Archive 5 - Aloe

Archive 6 - Coffee

Archive 7 - Wormwood

Archive 8 - Jasmine

Archive 9 - Mint

Archive 10 - Apple

Archive 12 - Carnation

Archive 13 - Orange

Archive 14 - Honey

Archive 15 - Pineapple

Archive 16 - Coconut

Archive 17 - Rose

Archive 18 - Pink Musk

Archive 19 - Lemon

Archive 20 - Strawberry

Archive 21 - Kapok

Archive 23 - Sandalwood